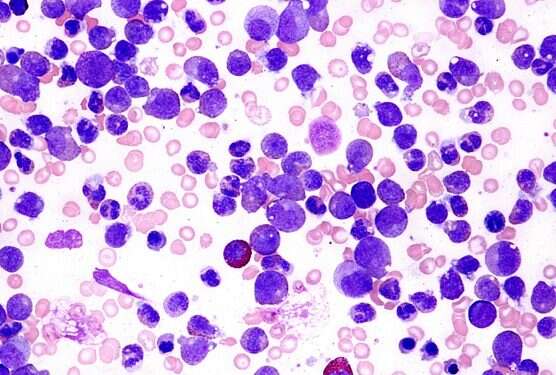
The drug attacks several leukemic proteins at once Israeli researchers develop groundbreaking leukemia drug

Researchers at the Hebrew University of Jerusalem have recently developed a breakthrough biological drug to treat people suffering from acute myeloid leukemia.
AML is one of the most aggressive cancers, and while other cancers have benefited from new treatments, there has been little encouraging news for most leukemia patients for the past 40 years, the researchers said in a statement.
AML is a type of cancer in which the bone marrow makes abnormal myeloblasts, a type of white blood cell, red blood cells or platelets.
Some 300 people in Israel are diagnosed with AML per year (0.8% of all cancer diagnoses), around half of them children.
Leukemia is difficult to treat because the variety and quantity of proteins it produces enable cancerous cells to grow rapidly and protect them against chemotherapy treatments.
The new drug developed by Professor Yinon Ben-Neriah and his research team at the Hebrew University of Jerusalem's Faculty of Medicine functions like a "cluster bomb," the researchers said.
The molecule they developed – by chemically manipulating a cancer cell – attacks several leukemic proteins at once, making it difficult for the leukemia cells to activate additional proteins to evade therapy.
"The single molecule targets many leukemia proteins at once and destroys all of the oncogenes, and activates the tumor suppressor P53 gene," said Ben-Neriah.
The drug has a 50% cure rate for lab mice injected with acute leukemia, researchers said, adding that they saw "a dramatic change" even after only a single dose of the new drug.
"Nearly all of the lab mice's leukemia signs disappeared overnight," Ben-Neriah said.
The molecule "worked very well with mice," he said, both in mice that had leukemia and those injected with human leukemia. "It worked even on the most aggressive [form] of human leukemia" injected into the mice.
The trailblazing research was conducted in conjunction with the Dr. Miriam and Sheldon G. Adelson Medical Research Foundation.
AML is currently treated with chemotherapy and stem cell injections.
The single-molecule drug, however, is being developed in pill form, not an injection, Ben-Neriah added.
According to the researchers, it accomplishes the work of three or four separate drugs, reducing cancer patients' need to be exposed to several therapies and to deal with their often unbearable side effects.
Ben-Neriah said he hoped the Phase 1 clinical study will start in the U.S. at the beginning of 2019. It will take a minimum of two to three years before the drug can be commercialized, he said.
The researchers are also trying to expand the drug's use to other cancers, including lymphoma, multiple myeloma, melanoma and colorectal cancer.
Dr. Miriam and Sheldon Adelson own the company that is the primary shareholder of Israel Hayom.

!['Long-term infections allow the virus to explore ways to infect cells more efficiently, and [this study] adds to the evidence that more transmissible variants have emerged from such infections,' Harvard University epidemiologist William Hanage says. Researchers discover Israeli coronavirus variant, but risk low](https://www.israelhayom.com/wp-content/uploads/2021/03/GettyImages-1209688759-350x250.jpg)